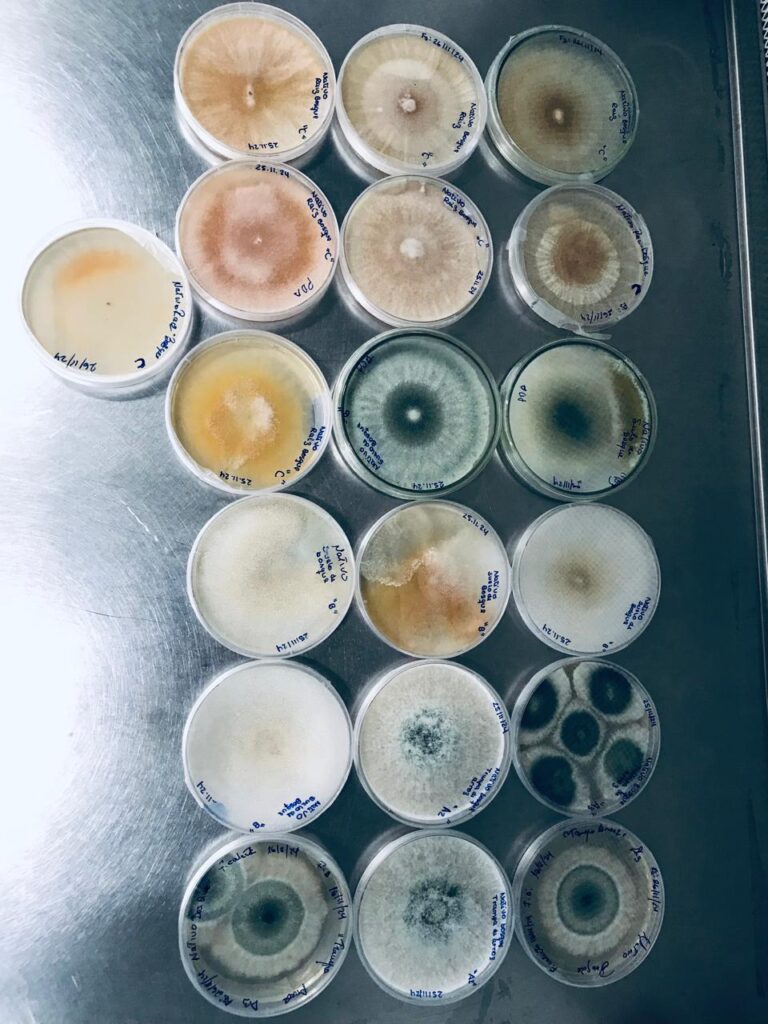

Sectour
Biotechnologie
Secteurs

La science a incontestablement contribué au progrès de la civilisation dans laquelle nous vivons aujourd’hui. De la découverte de la pénicilline à la création de systèmes robotiques autonomes, elle a amélioré la qualité de vie. L’intelligence humaine et la quête constante d’innovation ont permis le développement de technologies et de procédés adaptables à différents secteurs et domaines.
La biotechnologie est née dans ce contexte, cherchant à exploiter la sagesse de la nature pour créer de la technologie. Cette science peut être définie comme l’utilisation d’organismes vivants pour opérer des processus de transformation, en exploitant leurs bienfaits ou en tirant parti de leurs caractéristiques pour créer des produits ou services spécifiques à l’usage humain.
Chez Stinville Biotech, les projets de recherche se concentrent sur la culture du sacha inchi, une plante originaire du Pérou dont les fruits contiennent l’une des graines les plus riches en oméga-3 au monde.
Nous menons actuellement deux projets clés de recherche et développement qui reflètent notre engagement en faveur du développement durable et de l’innovation scientifique :
La production de Trichoderma harzianum et le développement d'engrais organique à partir de la mouche soldat noire.
Trichoderma harzianum est un champignon bénéfique largement étudié qui agit directement dans le sol, protégeant les cultures des maladies et favorisant une croissance saine. Dans l’écosystème agricole, il remplit deux fonctions principales :
- Biocontrôle : combat les champignons phytopathogènes, les bactéries et les nématodes, en plus d'induire une résistance systémique chez les plantes.
- Biostimulant : améliore la solubilisation des nutriments et favorise la production naturelle d'hormones végétales.
Ce micro-organisme colonise la rhizosphère et son efficacité dépend largement de son origine géographique. Chaque échantillon isolé, ou souche, présente des caractéristiques uniques dans son interaction avec le sol et le climat. Depuis 2021, nous travaillons avec une souche mère sélectionnée pour sa grande efficacité et prévoyons d’étendre nos recherches aux souches indigènes de nos parcelles de sacha inchi, afin d’identifier et de reproduire celles qui sont les mieux adaptées à l’environnement amazonien.
Cet engrais innovant, connu sous le nom de frass, est obtenu par bioconversion, un processus dans lequel les larves de l’espèce Hermetia illucens (mouche soldat noire) transforment les déchets organiques frais en un engrais de haute valeur agricole.
Bien que cette technologie soit déjà bien implantée en Europe et en Asie, elle en est encore à ses balbutiements au Pérou. Notre avantage concurrentiel réside dans le climat subtropical de la région de San Martín, idéal pour le développement naturel de cette espèce indigène, réduisant ainsi les coûts associés aux environnements à température contrôlée.
En octobre 2024, nous avons officialisé un partenariat public-privé avec la municipalité du district de La Banda de Shilcayo, inaugurant l’usine pilote de valorisation des déchets organiques à base de larves de mouches soldats noires, située dans la pépinière du district. Ce projet pionnier dans le pays vise à réduire les déchets organiques ménagers grâce à des cycles de bioconversion de 15 à 20 jours. Le compost ainsi obtenu sera initialement utilisé pour tester les cultures de sacha inchi.
Certains avantages que les excréments apportent au sol et aux plantes sont :
- Matière organique
- Rétention d'humidité
- Nutriments
- Chitine


